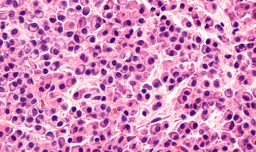

Google Vision
![]() | AI-Driven ECG Analysis Accurately Predicts Right-Side Heart IssuesHealth IT Analytics - (Tuesday January 9, 2024) - AI / Daily Reads / Health IT Analytics | |||
| ||||
![]() | Pharmacy Interoperability and Pharmacy Perspectives Coming Out of the ONC Annual MeetingHealthcare IT Today - (Tuesday January 9, 2024) - Healthcare IT Today / Videos | |||
| ||||
![]() | Making Informed Decisions: What You Need to Know Before Hiring a Software Expert for a Healthcare ProjectHIT Consultant - (Tuesday January 9, 2024) - Frequent Updates / HIT Consultant | |||
| ||||
![]() | DHSC to act on recommendation to increase use of digital pathologyDigital Health - (Tuesday January 9, 2024) - Digital Health / Frequent Updates | |||
| ||||
![]() | Indonesia expands robotic telesurgery project with IranHealthcare IT news - (Tuesday January 9, 2024) - Frequent Updates / Healthcare IT News | |||
| ||||
![]() | China doubles down on smart medicineHealthcare IT news - (Tuesday January 9, 2024) - Frequent Updates / Healthcare IT News | |||
| ||||
![]() | Intelligent Ultrasound launch AI software for gestational age estimationDigital Health - (Tuesday January 9, 2024) - AI / Digital Health / Frequent Updates | |||
| ||||
![]() | Qure.ai’s Breakthrough in Lung Nodule Detection | AI InnovationsDistilINFO Hospital IT - (Tuesday January 9, 2024) - Daily Reads / DistilINFO Hospital IT | |||
| ||||
![]() | Revolutionizing Healthcare | UpDoc’s Breakthrough in AI-Powered Patient CareDistilINFO Hospital IT - (Tuesday January 9, 2024) - Daily Reads / DistilINFO Hospital IT | |||
| ||||
![]() | Vanderbilt Explores AI | Advancing Healthcare InnovationsDistilINFO Hospital IT - (Tuesday January 9, 2024) - AI / Daily Reads / DistilINFO Hospital IT | |||
| ||||